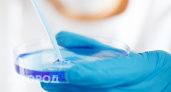
В Коми продолжается вакцинация

Автор материалов: Дмитрий Толстенёв
Последние новости
1 ведро в теплицу — и слабая рассада томатов крепнет: как дачникам помогает обычный мёд
13:45В Коми за сутки в ДТП пострадали ребенок-велосипедист и пассажир иномарки
12:45Ученые назвали самый полезный гриб - и это не шампиньоны, не вешенки и в разы полезнее опят
12:45Дачный старт за копейки: что я нашла в Fix Price — и выглядит это как из дорогого садового магазина
12:30Нетрезвый водитель иномарки не справился с управлением и съехал в кювет в Коми
11:45Эксперты ожидают появление первых клещей в Коми в начале апреля
11:07С апреля будем оплачивать воду и свет по-новому: вот что нужно знать, чтобы не переплатить
11:00Город, основанный в 1152 году: жемчужина Золотого кольца и колыбель русских озёр и древних белокаменных храмов — что посмотреть
11:00Жительницу Коми оштрафовали за листовки с гербом СССР на дверях подъезда
10:55Теперь моя морковка всегда всходит рано. Дедушка сосед рассказал, что для этого нужно сделать – урожая стало в 3 раза больше
10:47Комфортной погоды больше не будет: синоптики опубликовали тревожный прогноз на конец марта
10:15После схода снега вношу эту подкормку для чеснока – залог богатого урожая
10:02Роза-мечта для занятых: этот неубиваемый сорт цветет пышно до глубокой осени, не ломается от ветра и дождя
09:44Лью под куст после схода снега - и вишня растет крупная как грецкий орех. Одна подкормка весной решает всё
09:42В Коми банковский работник пресек попытку кражи крупной суммы у пенсионера
09:40Как жителям Коми оспорить новые строки в квитанциях за ЖКУ: инструкция эксперта по проверке законности начислений
09:10Дорожные камеры ускорили взыскание миллионных долгов в Коми
09:00Жертва телефонных мошенников проведет в СИЗО почти девять месяцев по обвинению в терроризме в Коми
09:00Врачи в Коми спасли 52-летнего пациента методом стентирования
08:48Власти Коми построят семь спортивных площадок возле школ в 2026 году
08:45Пионам в апреле обязательно: 2 ложки на ведро – и всё лето наслаждаюсь пышными соцветиями
07:50"На российский юг больше ни ногой". Туристы в шоке от курортов Краснодарского края на Чёрном море
07:37Имитация оплаты на кассе самообслуживания привела жителя Коми к штрафу
07:30Ярче «Шубы» и лучше винегрета: готовлю необычный салат из свеклы – рецепт из простых ингредиентов
07:03Суд Коми приговорил мужчину к 4,5 годам колонии за ранение сожительницы и атаку на полицейского
07:00Онлайн-курсы и возврат денег: суд в Ухте встал на сторону образовательной платформы
06:45Такой минтай не будет сухим: мой секретный соус с дижонской горчицей для сочности – на ужин готовлю только так
06:26Не хлебный мякиш и не сало: вот что нужно добавить в фарш для сочности и вкуса - котлеты получаются "пуховыми" и нежнейшими
06:03Почему желтеет лук на грядке - и чем полить, чтобы не желтел: простой способ решения частой проблемы
05:55Прогноз погоды в Республике Коми на 26 марта: в южных районах потеплеет до +13 градусов
05:455 минут, и унитаз как новый: простой способ вернуть белизну без дорогих средств
05:03Признания проводницы РЖД: "За занавесками в плацкарте охи-вздохи, и каждый рейс у людей что-нибудь пропадает"
04:24В марте и апреле от тли мощнее нет: 5 капель в воду и паразиты отползут на километр - эффект на весь сезон
04:03Эти ягоды пахнут мёдом, а на вкус — настоящий десерт: топ-3 сортов, отличный урожай при любой погоде
04:02Нитяные шторы - прошлый век: вот чем дизайнеры предлагают заменить их в современном интерьере
03:30


2 сосногорских уголовника заключены под стражу в Ухте
5 декабря 2023
Ухтинке присвоили специальное полицейское звание
5 декабря 2023
В Сосногорске выявили большое количество пьяных водителей
5 декабря 2023